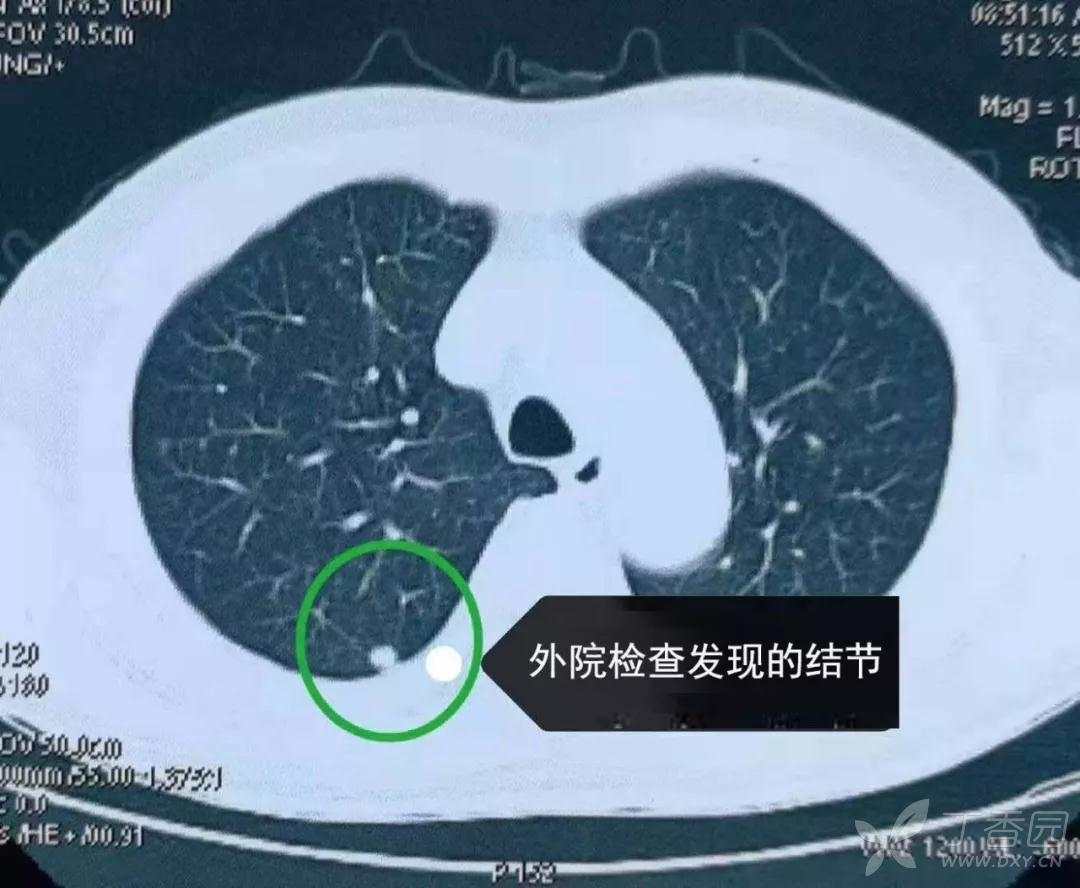
小结节随访未变化,右肺下叶出现新发病灶 - 丁香园论坛

小结节

这个爱美女士的肺部小结节暂时不需要手术! - 好大夫在线
图片尺寸1107x1080
一照ct肺有小结节我会是肺癌吗
图片尺寸1840x3264
肺部小结节
图片尺寸861x609
是不是50岁左右的人,如果有肺小结节,恶性可能更大?
图片尺寸1564x1723
肺小结节 肺上的一个小结节,肉眼观境界不是非常清楚.镜下 - 抖音
图片尺寸1128x1920
这个小结节是良性的但我却高兴不起来
图片尺寸1913x1562
肺小结节该怎么定位除了有创还有这种方法
图片尺寸1080x1440
发现双肺下叶小结节会是恶性的吗?马上戒烟能消失吗?
图片尺寸640x417
肺部小结节
图片尺寸3264x2448
胸腔镜微创手术中各种定位肺小结节/磨玻璃结节的方法!
图片尺寸1299x756
不容忽视的肺小结节
图片尺寸1310x1080
恶行肺部小结节的不同形态
图片尺寸700x938
恶行肺部小结节的不同形态
图片尺寸700x940
体检发现肺部小结节,请教!
图片尺寸1202x761
胸外科医生有肺小结节怎么办
图片尺寸3264x1840
一照ct肺有小结节我会是肺癌吗
图片尺寸3264x1840
肺部小结节
图片尺寸640x525
肺部小结节半年后复查_肺部小结节_医疗健康_医疗健康其他
图片尺寸1080x833
双肺外周多发小结节,斑点样病灶
图片尺寸640x480
小结节随访未变化,右肺下叶出现新发病灶 - 丁香园论坛
图片尺寸1080x888